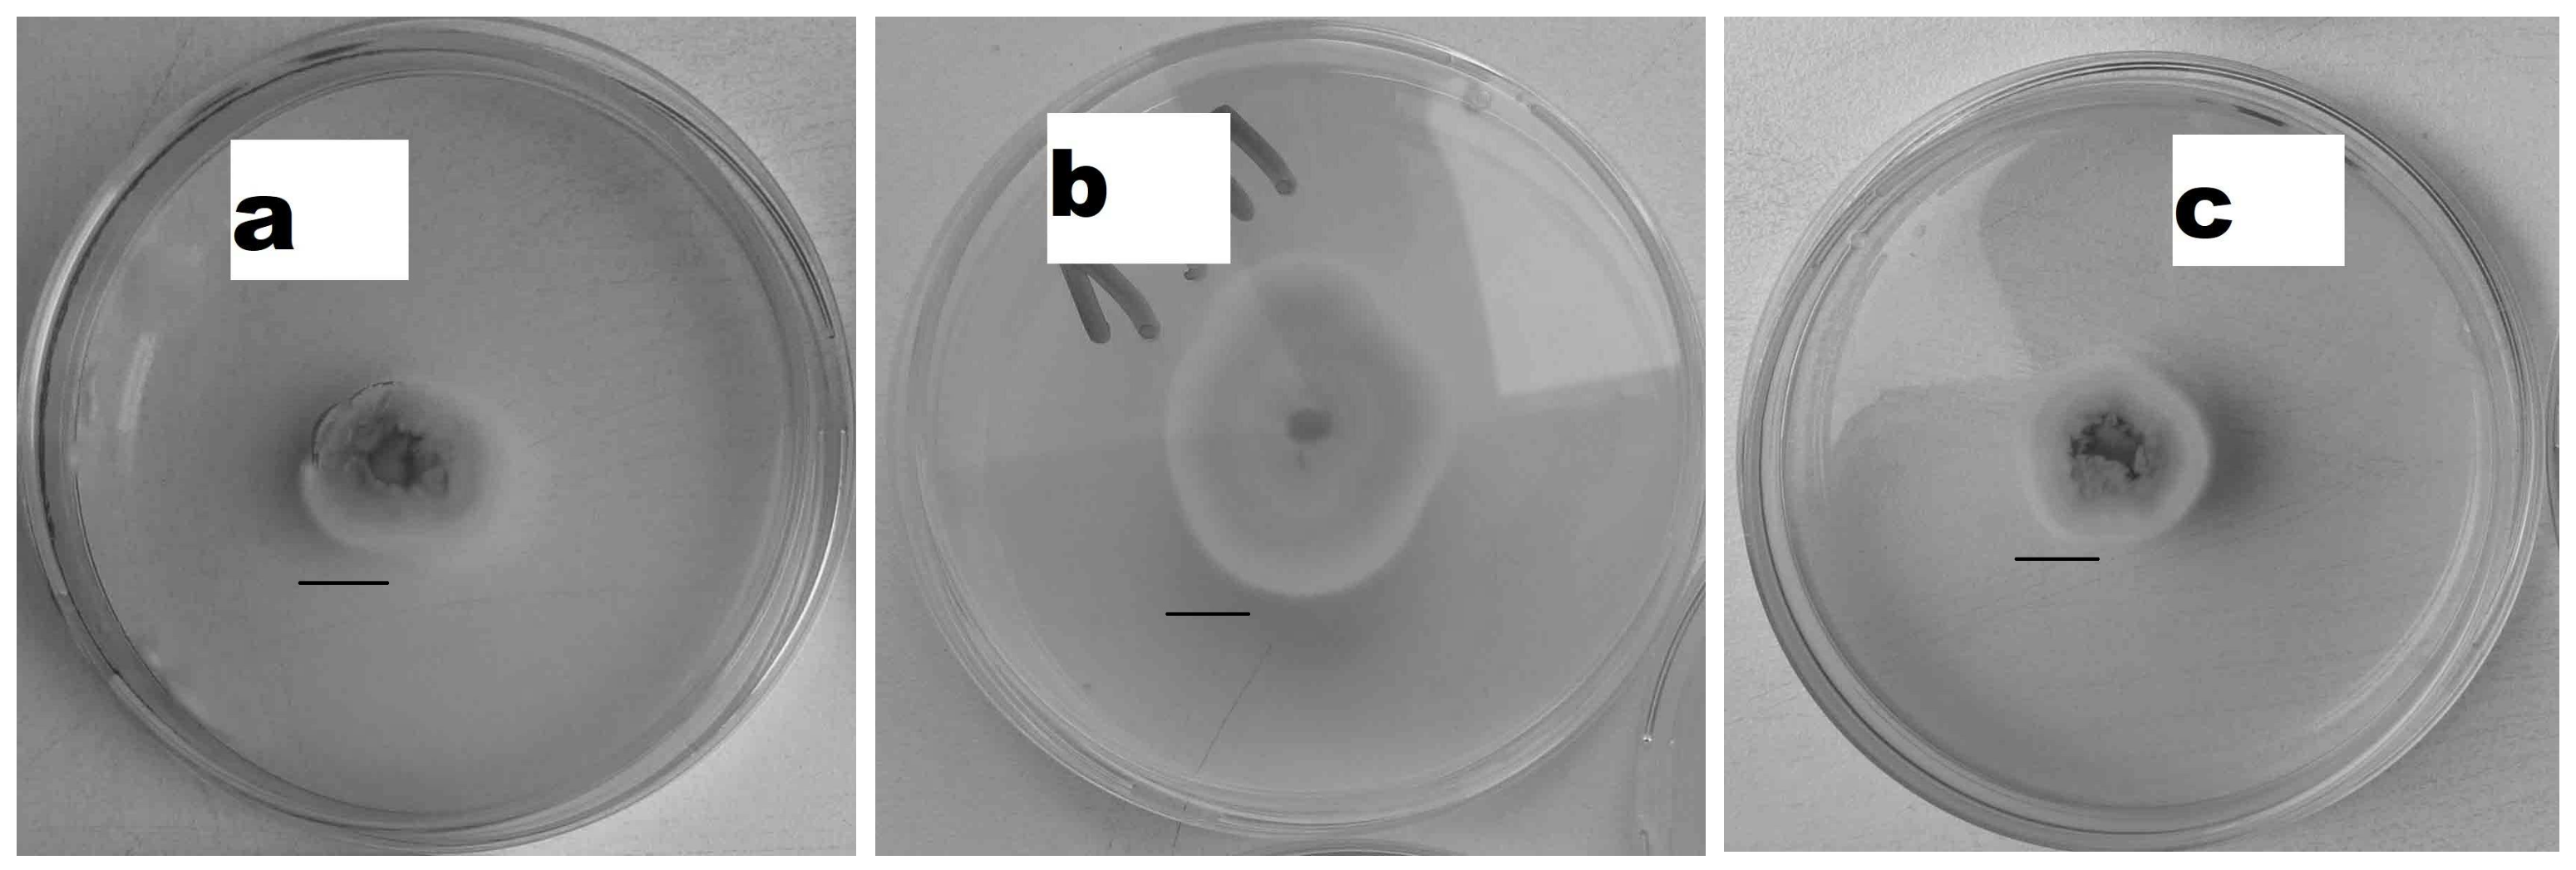
Applsci 14 11508 g002

The Effect of Exposure to an Electromagnetic Field on Entomopathogenic Fungi
Abstract
Featured Application
Abstract
1. Introduction
2. Materials and Methods
2.1. Biological Material
2.2. Electromagnetic Field
2.3. The Effect of EMFs on Fungi
2.4. Statistical Analyses
3. Results
4. Discussion
5. Conclusions
- The reaction of B. bassiana, C. fumosorosea, and M. anisopliae to EMF exposure depended on the investigated fungus species and the applied frequency.
- Exposure to a 900 MHz electromagnetic field stimulated the linear growth of the mycelium of B. bassiana and C. fumosorosea and the pathogenicity of C. fumosorosea.
- Exposure to a 900 MHz electromagnetic field stimulated the sporulation of the entomopathogenic fungus M. anisopliae.
- A 1800 MHz electromagnetic field inhibited the sporulation and spore germination of B. bassiana.
- The study suggests the need for further studies on the effect of a 900 MHz electromagnetic field on the growth and pathogenicity of the entomopathogenic fungi B. bassiana, C. fumosorosea, and M. anisopliae.
Author Contributions
Funding
Institutional Review Board Statement
Informed Consent Statement
Data Availability Statement
Conflicts of Interest
References
- Lutz, K.; Cadiou, H.; Trevino, T.; Cinelli, F.I. Electromagnetic Fields to Sustain Life on Earth, in Space, and Planets. In Proceedings of the 72nd International Astronautical Congress (IAC), Dubai, United Arab Emirates, 25–29 October 2021. [Google Scholar]
- Gye, M.C.; Park, C.J. Effect of electromagnetic field exposure on the reproductive system. Clin. Exp. Reprod. Med. 2012, 39, 1–9. [Google Scholar] [CrossRef]
- Staebler, P. Sources of Electromagnetic Fields. In Human Exposure to Electromagnetic Fields: From Extremely Low Frequency (ELF) to Radiofrequency; John Wiley and Sons, Inc.: Hoboken, NJ, USA, 2017; pp. 35–88. [Google Scholar] [CrossRef]
- Ouadah, N.S.; Lecomte, A.; Robidel, F.; Olsson, A.; Deltour, I.; Schüz, J.; Blazy, K.; Villégier, A.S. Possible effects of radiofrequency electromagnetic fields on in vivo C6 brain tumors in Wistar rats. J. Neurooncol. 2018, 140, 539–546. [Google Scholar] [CrossRef]
- Pawlak, K.; Sechman, A.; Nieckarz, Z.; Wojtysiak, D. Effect of weak electromagnetic field on cardiac work, concentration of thyroid hormones and blood aminotransferase level in the chick embryo. Acta Vet. Hung. 2013, 61, 383–392. [Google Scholar] [CrossRef]
- Christopoulou, M.; Karabetsos, E. Evaluation of Radiofrequency and Extremely Low-Frequency Field Levels at Children’s Playground Sites in Greece from 2013 to 2018. Bioelectromagnetics 2019, 40, 602–605. [Google Scholar] [CrossRef]
- Cucurachi, S.; Tamis, W.L.M.; Vijver, M.G.; Peijnenburg, W.J.G.M.; Bolte, J.F.B.; de Snoo, G.R. A review of the ecological effects of radiofrequency electromagnetic fields (RF-EMF). Environ. Int. 2013, 51, 116–140. [Google Scholar] [CrossRef] [PubMed]
- Czerwiński, M.; Vian, A.; Woodcock, B.A.; Goliński, P.; Virto, L.R.; Januszkiewicz, Ł. Do electromagnetic fields used in telecommunications affect wild plant species? A control impact study conducted in the field. Ecol. Indic. 2023, 150, 110267. [Google Scholar] [CrossRef]
- Said-Salman, I.H.; Jebaii, F.A.; Yusef, H.H.; Moustafa, M.E. Evaluation of Wi-Fi Radiation Effects on Antibiotic Susceptibility, Metabolic Activity and Biofilm Formation by Escherichia coli 0157H7, Staphylococcus aureus and Staphylococcus epidermis. J. Biomed. Phys. Eng. 2019, 9, 579–586. [Google Scholar]
- Crabtree, D.P.E.; Herrera, B.J.; Kang, S. The response of human bacteria to static magnetic field and radiofrequency electromagnetic field. J. Microbiol. 2017, 55, 809–815. [Google Scholar] [CrossRef]
- Koyama, S.; Takashima, Y.; Sakurai, T.; Suzuki, Y.; Taki, M.; Miyakoshi, J. Effects of 2.45 GHz electromagnetic fields with a wide range of SARs on bacterial and HPRT gene mutations. J. Radiat. Res. 2007, 48, 69–75. [Google Scholar] [CrossRef] [PubMed]
- Chang, S.K.; Choi, J.S.; Gil, H.W.; Yang, J.O.; Lee, E.Y.; Jeon, Y.S.; Lee, Z.W.; Lee, M.; Hong, M.Y.; Ho Son, T.; et al. Genotoxicity evaluation of electromagnetic fields generated by 835-MHz mobile phone frequency band. Eur. J. Cancer Prev. 2005, 14, 175–179. [Google Scholar] [CrossRef] [PubMed]
- Choe, M.; Choe, W.; Cha, S.; Lee, I. Changes of cationic transport in AtCAX5 transformant yeast by electromagnetic field environments. J. Biol. Phys. 2018, 44, 433–448. [Google Scholar] [CrossRef] [PubMed]
- Riffo, B.; Henríquez, C.; Chávez, R.; Peña, R.; Sangorrín, M.; Gil-Duran, C.; Rodríguez, A.; Ganga, M.A. Nonionizing Electromagnetic Field: A Promising Alternative for Growing Control Yeast. J. Fungi 2021, 7, 281. [Google Scholar] [CrossRef] [PubMed]
- Perez, V.H.; Reyes, A.F.; Justo, O.R.; Alvarez, D.C.; Alegre, R.M. Bioreactor coupled with electromagnetic field generator: Effects of extremely low frequency electromagnetic fields on ethanol production by Saccharomyces cerevisiae. Biotechnol. Prog. 2007, 23, 1091–1094. [Google Scholar] [CrossRef] [PubMed]
- Veerana, M.; Yu, N.-N.; Bae, S.-J.; Kim, I.; Kim, E.-S.; Ketya, W.; Lee, H.-Y.; Kim, N.-Y.; Park, G. Enhancement of Fungal Enzyme Production by Radio-Frequency Electromagnetic Fields. J. Fungi 2022, 8, 1187. [Google Scholar] [CrossRef] [PubMed]
- Anaya, M.; Gámez-Espinosa, E.; Borrego, S.; Barbara, E. Magnetotropism: A tropic response of Candida guillemondii by the effect of the oscillating magnetic field of extremely low frequency. Air Qual. Atmos. Health 2023, 16, 2367–2376. [Google Scholar] [CrossRef]
- Luma, T.A.; Amer, D.M.; Saima’a, A.S. The effect of mobile waves on the growth of pathogenic Fungi. Int. J. Curr. Microbiol. Appl. Sci. 2015, 4, 838–842. [Google Scholar]
- Jaronski, S.T. Soil ecology of the entomopathogenic ascomycetes: A critical examination of what we (think) we know. In Use of Entomopathogenic Fungi in Biological Pest Management; Research Signpost: Trivandrum, India, 2007; pp. 91–144. [Google Scholar]
- Tkaczuk, C.; Tipping, C.; Majchrowska-Safaryan, A.; Król, A.; Wyrzykowska, M.; Wegensteiner, R. The occurrence of entomopathogenic fungi in soils from apple orchards protected in different farming systems. Fresen. Environ. Bull. 2019, 28, 7906–7914. [Google Scholar]
- Majchrowska-Safaryan, A.; Tkaczuk, C. Abundance of Entomopathogenic Fungi in Leaf Litter and Soil Layers in Forested Habitats in Poland. Insects 2021, 12, 134. [Google Scholar] [CrossRef]
- Mantzoukas, S.; Kitsiou, F.; Natsiopoulos, D.; Eliopoulos, P.A. Entomopathogenic Fungi: Interactions and Applications. Encyclopedia 2022, 2, 646–656. [Google Scholar] [CrossRef]
- Inglis, G.D.; Goettel, M.S.; Butt, T.M.; Strasser, H. Use of hyphomycetous fungi for managing insect pests: Fungi as Biocontrol Agents. In Progress, Problems and Potential; Butt, T.M., Jackson, C., Magan, N., Eds.; CABI Publishing: Wallingford, UK, 2001; pp. 23–69. [Google Scholar]
- Mantzoukas, S.; Eliopoulos, P.A. Endophytic Entomopathogenic Fungi: A Valuable Biological Control Tool against Plant Pests. Appl. Sci. 2020, 10, 360. [Google Scholar] [CrossRef]
- Mann, A.J.; Davis, T.S. Entomopathogenic fungi to control bark beetles: A review of ecological recommendations. Pest. Manag. Sci. 2021, 77, 3841–3846. [Google Scholar] [CrossRef] [PubMed]
- Skinner, M.; Parker, B.L.; Kim, J.S. Role of Entomopathogenic Fungi in Integrated Pest Management. In Integrated Pest Management; Dharam, P., Ed.; Academic Press: Cambridge, MA, USA, 2014; pp. 169–191. [Google Scholar] [CrossRef]
- Cafarchia, C.; Pellegrino, R.; Romano, V.; Friuli, M.; Demitri, C.; Pombi, M.; Benelli, G.; Otranto, D. Delivery and effectiveness of entomopathogenic fungi for mosquito and tick control: Current knowledge and research challenges. Acta Trop. 2022, 234, 106627. [Google Scholar] [CrossRef] [PubMed]
- Hoarau, C.; Campbell, H.; Prince, G.; Chandler, D.; Pope, T. Biological control agents against the cabbage stem flea beetle in oilseed rape crops. Biol. Control 2022, 167, 104844. [Google Scholar] [CrossRef]
- Mannino, M.C.; Huarte-Bonnet, C.; Davyt-Colo, B.; Pedrini, N. Is the Insect Cuticle the only Entry Gate for Fungal Infection? Insights into Alternative Modes of Action of Entomopathogenic Fungi. J. Fungi 2019, 5, 33. [Google Scholar] [CrossRef]
- Safavi, S.A.; Shah, F.A.; Pakdel, A.K.; Rasoulian, G.R.; Bandani, A.R.; Butt, T.M. Effect of nutrition on growth and virulence of the entomopathogenic fungus Beauveria bassiana. FEMS Microbiol. Lett. 2007, 270, 116–123. [Google Scholar] [CrossRef]
- Jaworska, M.; Ropek, D. Chemical stimulation of the virulence of entomopathogenic fungi. Arch. Phytopath Pflanz. 2000, 33, 219–223. [Google Scholar] [CrossRef]
- Jaworska, M.; Domanski, J.; Tomasik, P.; Znój, K. Stimulation of pathogenicity and growth of entomopathogenic fungi with static magnetic field. J. Plant Dis. Prot. 2006, 123, 295–300. [Google Scholar] [CrossRef]
- Inglis, G.D.; Enkerli, J.; Goettel, M.S. Manual of Techniques in Invertebrate Pathology. In Laboratory Techniques Used for Entomopathogenic Fungi: Hypocreales Chapter VII; Lacey, L.A., Ed.; Academic Press: London, UK, 2012; pp. 189–253. [Google Scholar]
- Pawlak, K.; Nieckarz, Z.; Sechman, A.; Wojtysiak, D.; Bojarski, B.; Tombarkiewicz, B. Effect of a 1800 MHz electromagnetic field emitted during embryogenesis on chick development and hatchability. Anat. Histol. Embryol. 2018, 47, 222–230. [Google Scholar] [CrossRef]
- Kursa, W.; Jamiołkowska, A.; Wyrostek, J.; Kowalski, R. Antifungal Effect of Plant Extracts on the Growth of the Cereal Pathogen Fusarium spp.—An In Vitro Study. Agronomy 2022, 12, 3204. [Google Scholar] [CrossRef]
- Gleń-Karolczyk, K.; Witkowicz, R.; Boligłowa, E. In vitro study on the use of quinoa (Chenopodium quinoa Willd.) extracts from to limit the development of phytopathogenic fungi. J. Res. Appl. Agric. Eng. 2016, 61, 132–138. [Google Scholar]
- Lipa, J.J.; Śliżyński, K. Wskazówki metodyczne i terminologia do wyznaczania średniej dawki śmiertelnej (LD50) w patologii owadów i toksykologii. Pr. Nauk. IOR 1973, 15, 59–82. [Google Scholar]
- Lopes, R.B.; Martins, I.; Souza, D.A.; Faria, M. Influence of some parameters on the germination assessment of mycopesticides. J. Invertebr. Pathol. 2013, 112, 236–242. [Google Scholar] [CrossRef]
- Faria, M.; Lopes, R.B.; Souza, D.A.; Wraight, S.P. Conidial vigor vs. viability as predictors of virulence of entomopathogenic fungi. J. Invertebr. Pathol. 2015, 125, 68–72. [Google Scholar] [CrossRef] [PubMed]
- StatSoft, Inc. 2014 STATISTICA (Data Analysis Software System), Version 12. Available online: www.statsoft.com (accessed on 1 December 2017).
- Jabłońska, J.; Dubrowska, K.; Gliźniewicz, M.; Paszkiewicz, O.; Augustyniak, A.; Grygorcewicz, B.; Konopacki, M.; Markowska-Szczupak, A.; Kordas, M.; Dołęgowska, B.; et al. Chapter Two—The use of the electromagnetic field in microbial process bioengineering. Adv. Appl. Microbiol. 2022, 121, 27–72. [Google Scholar] [CrossRef]
- Ružič, R.; Gogala, N.; Jerman, I. Sinusoidal Magnetic Fields: Effects on the Growth and Ergosterol Content in Mycorrhizal Fungi. Electro- Magnetobiology 1997, 16, 129–142. [Google Scholar] [CrossRef]
- Eliaš, D.; Tóth Hervay, N.; Gbelská, Y. Ergosterol Biosynthesis and Regulation Impact the Antifungal Resistance and Virulence of Candida spp. Stresses 2024, 4, 641–662. [Google Scholar] [CrossRef]
- Ruiz-Gómez, M.J.; Ristori-Bogajo, E.; Prieto-Barcia, M.I.; Martínez-Morillo, M. No Evidence of Cellular Alterations by MilliTesla-Level Static and 50 Hz Magnetic Fields on S. cerevisiae. Electromagn. Biol. Med. 2010, 29, 154–164. [Google Scholar] [CrossRef]
- Makarov, I.O.; Klyuev, D.A.; Smirnov, V.F.; Anikina, N.A.; Dikareva, N.V. Effect of Low-Frequency Pulsed Magnetic Field and Low-Level Laser Radiation on Oxidoreductase Activity and Growth of Fungi—Active Destructors of Polymer Materials. Microbiology 2019, 88, 72–78. [Google Scholar] [CrossRef]
- Albertini, M.C.; Accorsi, A.; Citterio, B.; Burattini, S.; Piacentini, M.P.; Uguccioni, F.; Piatti, E. Morphological and biochemical modifications induced by a static magnetic field on Fusarium culmorum. Biochimie 2003, 85, 963–970. [Google Scholar] [CrossRef]
- Nagy, P.; Fischl, G. Effect of static magnetic field on growth and sporulation of some plant pathogenic fungi. Bioelectromagnetics 2004, 25, 316–318. [Google Scholar] [CrossRef]
- Anaya, M.; Gámez-Espinosa, E.; Valdés, O.; Guzman, T.; Borrego, S. Effect of the oscillating magnetic field on airborne fungal. Arch. Microbiol. 2021, 203, 2139–2145. [Google Scholar] [CrossRef] [PubMed]
- Riquelme, M.; Aguirre, J.; Bartnicki-García, S.; Braus, G.H.; Feldbrügge, M.; Fleig, U.; Hansberg, W.; Herrera-Estrella, A.; Kämper, J.; Kück, U.; et al. Fungal Morphogenesis, from the Polarized Growth of Hyphae to Complex Reproduction and Infection Structures. Microbiol. Mol. Biol. Rev. 2018, 82, e00068-17. [Google Scholar] [CrossRef] [PubMed]
- Zhou, L.; Evangelinos, M.; Wernet, V.; Eckert Antonia, F.; Ishitsuka, Y.; Fischer, R.; Nienhaus, G.U.; Takeshita, N. Superresolution and pulse-chase imaging reveal the role of vesicle transport in polar growth of fungal cells. Sci. Adv. 2020, 4, e1701798. [Google Scholar] [CrossRef] [PubMed]
- Liebana-Jordan, M.; Brotons, B.; Falcon-Perez, J.M.; Gonzalez, E. Extracellular Vesicles in the Fungi Kingdom. Int. J. Mol. Sci. 2021, 22, 7221. [Google Scholar] [CrossRef] [PubMed] [PubMed Central]
- Steinberg, G. Hyphal growth: A tale of motors, lipids, and the Spitzenkörper. Eukaryot. Cell. 2007, 6, 351–360. [Google Scholar] [CrossRef] [PubMed] [PubMed Central]
- Balmant, W.; Sugai-Guérios, M.H.; Coradin, J.H.; Krieger, N.; Junior, A.F.; Mitchell, D.A. A Model for Growth of a Single Fungal Hypha Based on Well-Mixed Tanks in Series: Simulation of Nutrient and Vesicle Transport in Aerial Reproductive Hyphae. PLoS ONE 2015, 10, e0120307. [Google Scholar] [CrossRef]
- Piątkowski, J.; Krzyżewska, A. Influence of some physical factors on the growth and sporulation of entomopathogenic fungi. Acta Mycol. 2007, 42, 255–265. [Google Scholar] [CrossRef]
- Borisade, O.A.; Magan, N. Growth and sporulation of entomopathogenic Beauveria bassiana, Metarhizium anisopliae, Isaria farinosa and Isaria fumosorosea strains in relation to water activity and temperature interactions. Biocontrol. Sci. Technol. 2014, 24, 999–1011. [Google Scholar] [CrossRef]
- Steffen, R.; Steffen, K.; Maldaner, J. In Vitro Activation of Microbial Growth in Low Frequency Electromagnetic Fields. J. Agric. Environ. Sci. 2020, 9, 1–7. [Google Scholar] [CrossRef]
- Jenkins, N.E.; Grzywacz, D. Quality control of fungal and viral biocontrol agent–assurance of product performance. Biocontrol Sci. Technol. 2000, 10, 753–777. [Google Scholar] [CrossRef]
- Mwamburi, L.A.; Laing, M.D.; Miller, R.M. Effect of surfactants and temperature on germination and vegetative growth of Beauveria bassiana. Braz. J. Microbiol. 2015, 46, 67–74. [Google Scholar] [CrossRef]
- Moldovan, A.; Munteanu-Molotievskiy, N.; Toderas, I. Temperature effects on the entomopathogenic fungi Beauveria bassiana strain cnmn-fe-01: Vegetative growth, sporulation, germination rate. Curr. Trends Nat. Sci. 2022, 11, 332–338. [Google Scholar] [CrossRef]
- Liu, H.; Zhao, X.; Guo, M.; Liu, H.; Zheng, Z. Growth and metabolism of Beauveria bassiana spores and mycelia. BMC Microbiol. 2015, 15, 267. [Google Scholar] [CrossRef] [PubMed]
- Liu, Z.; Lei, Z.; Hua, B.; Wang, H.; Liu, T. Germination behavior of Beauveria bassiana (Deuteromycotina: Hyphomycetes) on Bemisia tabaci (Hemiptera: Aleyrodidae) nymphs. J. Entomol. Sci. 2010, 45, 322–334. [Google Scholar] [CrossRef]
- Sztafrowski, D.; Suchodolski, J.; Muraszko, J.; Sigler, K.; Krasowska, A. The influence of N and S poles of static magnetic field (SMF) on Candida albicans hyphal formation and antifungal activity of amphotericin B. Folia Microbiol. 2019, 64, 727–734. [Google Scholar] [CrossRef]
- Quesada-Moraga, E.; González-Mas, N.; Yousef-Yousef, M.; Garrido-Jurado, I.; Fernandez-Bravo, M. Key role of environmental competence in successful use of entomopathogenic fungi in microbial pest control. J. Pest. Sci. 2023, 97, 1–15. [Google Scholar] [CrossRef]
- Saputro, T.B.; Prayogo, Y.; Rohman, F.L.; Alami, N.H. The virulence improvement of Beauveria bassiana in infecting Cylas formicarius modulated by various chitin based compounds. Biodiversitas 2019, 20, 2486–2493. [Google Scholar] [CrossRef]
- Stuart, A.K.d.C.; Furuie, J.L.; Cataldi, T.R.; Stuart, R.M.; Zawadneak, M.A.C.; Labate, C.A.; Pimental, I.C. Fungal consortium of two Beauveria bassiana strains increases their virulence, growth, and resistance to stress: A metabolomic approach. PLoS ONE 2022, 17, e0271460. [Google Scholar] [CrossRef]
- Oyarce, G.; Bravo-Arrepol, G.; Trivino, S.; Nanco, F.; Hasbun, R.; Perez, C.; Becerra, J.; Torres, S. Effect of WiFi radiofrequencies on the content of fatty acid and ergosterol, a precursor of vitamin D in in-vitro cultures of the fungus Serpula himantioides. J. Chillean Chem. Soc. 2021, 66, 5125–5129. [Google Scholar] [CrossRef]
- Ajmal, M.; Hussain, A.; Ali, A.; Chen, H.; Lin, H. Strategies for Controlling the Sporulation in Fusarium spp. J. Fungi 2023, 9, 10. [Google Scholar] [CrossRef]
- Dias, L.P.; Pupin, B.; Roberts, D.W.; Rangel, D.E.N. Low- or high-white light irradiance induces similar conidial stress tolerance in Metarhizium robertsii. Arch. Microbiol. 2022, 204, 83. [Google Scholar] [CrossRef]
- Dias, L.P.; Souza, R.K.F.; Pupin, B.; Rangel, D.E.N. Conidiation under illumination enhances conidial tolerance of insect-pathogenic fungi to environmental stresses. Fungal Biol. 2021, 125, 891–904. [Google Scholar] [CrossRef] [PubMed]

| Treatment | Fungi Species Colony Diameter [cm] ± SD | ||
|---|---|---|---|
| B. bassiana | C. fumosorosea | M. anisopliae | |
| Control | 2.20 abc ± 0.268 | 2.87 cd ± 0.160 | 2.15 abc ± 0.065 |
| 900 MHz | 3.12 d ± 0.210 | 4.02 e ± 0.025 | 2.87 cd ± 0.240 |
| 1800 MHz | 1.91 a ± 0.074 | 2.77 bcd ± 0.062 | 2.07 ab ± 0.070 |
| Treatment | Fungi Species Inhibition/Stimulation Coefficient [%] ± SD | ||
|---|---|---|---|
| B. bassiana | C. fumosorosea | M. anisopliae | |
| 900 MHz | −42.0 a ± 9.53 | −40.0 a ± 0.87 | −33.7 a ± 11.13 |
| 1800 MHz | 13.1 b ± 3.34 | 3.7 b ± 2.14 | 3.5 b ± 3.28 |
| Treatment | Fungi Species Colony Diameter [cm] ± SD | ||
|---|---|---|---|
| B. bassiana | C. fumosorosea | M. anisopliae | |
| Control | 6.45 b ± 0.202 | 7.25 c ± 0.132 | 7.35 c ± 0.096 |
| 900 MHz | 7.27 c ± 0.085 | 8.10 d ± 0.071 | 8.30 d ± 0.071 |
| 1800 MHz | 6.05 a ± 0.096 | 7.05 c ± 0.119 | 7.20 c ± 0.041 |
| Treatment | Fungi Species Inhibition/Stimulation Coefficient [%] ± SD | ||
|---|---|---|---|
| B. bassiana | C. fumosorosea | M. anisopliae | |
| 900 MHz | −12.8 a ± 1.32 | 11.7 a ± 0.97 | −12.9 a ± 0.96 |
| 1800 MHz | 6.2 b ± 1.48 | 2.7 b ± 1.64 | 2.0 b ± 0.55 |
| Treatment | Fungi Species Number of Spores [108] ± SD | ||
|---|---|---|---|
| B. bassiana | C. fumosorosea | M. anisopliae | |
| Control | 1.82 b ± 0.042 | 19.8 c ± 0.312 | 28.4 de ± 0.591 |
| 900 MHz | 1.93 b ± 0.027 | 22.5 cd ± 0.382 | 32.9 e ± 0.842 |
| 1800 MHz | 1.42 a ± 0.062 | 18.0 c ± 0.405 | 28.5 de ± 0.431 |
| Treatment | Fungi Species Inhibition/Stimulation Coefficient [%] ± SD | ||
|---|---|---|---|
| B. bassiana | C. fumosorosea | M. anisopliae | |
| 900 MHz | −6.0 a ± 1.49 | −14.0 a ± 1.93 | −15.8 a ± 2.97 |
| 1800 MHz | 22.0 b ± 3.42 | 8.9 b ± 2.05 | −0.5 b ± 1.52 |
| Treatment | Fungi Species Percent of Germinating Spores ± SD | ||
|---|---|---|---|
| B. bassiana | C. fumosorosea | M. anisopliae | |
| Control | 98.3 d ± 0.48 | 99.3 d ± 0.48 | 95.0 cd ± 1.29 |
| 900 MHz | 85.5 a ± 2.75 | 96.8 d ± 0.48 | 91.8 bc ± 0.85 |
| 1800 MHz | 86.5 a ± 2.22 | 88.8 ab ± 1.25 | 95.8 cd ± 0.75 |
| Treatment | Fungi Species Inhibition/Stimulation Coefficient [%] ± SD | ||
|---|---|---|---|
| B. bassiana | C. fumosorosea | M. anisopliae | |
| 900 MHz | 12.9 a ± 2.80 | 2.5 a ± 0.48 | 3.4 b ± 0.89 |
| 1800 MHz | 11.9 a ± 2.26 | 10.6 b ± 1.26 | −0.8 a ± 0.79 |
| Treatment | Fungi Species Germ Tube Length [µm] ± SD | ||
|---|---|---|---|
| B. bassiana | C. fumosorosea | M. anisopliae | |
| Control | 2.47 abc ± 0.096 | 3.43 bcd ± 0.148 | 2.56 abc ± 0.053 |
| 900 MHz | 2.12 ab ± 0.073 | 4.16 cd ± 0.170 | 4.66 d ± 0.257 |
| 1800 MHz | 0.98 a ± 0.381 | 4.77 d ± 0.342 | 1.82 ab ± 0.331 |
| Treatment | Fungi Species Inhibition/Stimulation Coefficient [%] ± SD | ||
|---|---|---|---|
| B. bassiana | C. fumosorosea | M. anisopliae | |
| 900 MHz | 14.3 a ± 2.93 | −21.3 a ± 4.96 | 82.5 a ± 10.05 |
| 1800 MHz | 60.5 b ± 15.40 | −39.1 a ± 9.96 | 28.9 b ± 12.95 |
| Treatment | Fungi Species Mortality of Larvae [%] | ||
|---|---|---|---|
| B. bassiana | C. fumosorosea | M. anisopliae | |
| Control | 87.5 ab ± 4.78 | 80.0 a ± 4.08 | 90.0 ab ± 4.08 |
| 900 MHz | 87.5 ab ± 2.50 | 97.5 b ± 2.50 | 90.0 ab ± 4.08 |
| 1800 MHz | 67.5 a ± 2.50 | 77.5 a ± 2.50 | 87.5 ab ± 2.50 |
Disclaimer/Publisher’s Note: The statements, opinions and data contained in all publications are solely those of the individual author(s) and contributor(s) and not of MDPI and/or the editor(s). MDPI and/or the editor(s) disclaim responsibility for any injury to people or property resulting from any ideas, methods, instructions or products referred to in the content. |
© 2024 by the authors. Licensee MDPI, Basel, Switzerland. This article is an open access article distributed under the terms and conditions of the Creative Commons Attribution (CC BY) license (https://creativecommons.org/licenses/by/4.0/).
Share and Cite
Ropek, D.R.; Frączek, K.; Pawlak, K.; Bulski, K.; Ludwiczak, M. The Effect of Exposure to an Electromagnetic Field on Entomopathogenic Fungi. Appl. Sci. 2024, 14, 11508. https://doi.org/10.3390/app142411508
Ropek DR, Frączek K, Pawlak K, Bulski K, Ludwiczak M. The Effect of Exposure to an Electromagnetic Field on Entomopathogenic Fungi. Applied Sciences. 2024; 14(24):11508. https://doi.org/10.3390/app142411508
Chicago/Turabian StyleRopek, Dariusz Roman, Krzysztof Frączek, Krzysztof Pawlak, Karol Bulski, and Magdalena Ludwiczak. 2024. "The Effect of Exposure to an Electromagnetic Field on Entomopathogenic Fungi" Applied Sciences 14, no. 24: 11508. https://doi.org/10.3390/app142411508
APA StyleRopek, D. R., Frączek, K., Pawlak, K., Bulski, K., & Ludwiczak, M. (2024). The Effect of Exposure to an Electromagnetic Field on Entomopathogenic Fungi. Applied Sciences, 14(24), 11508. https://doi.org/10.3390/app142411508

